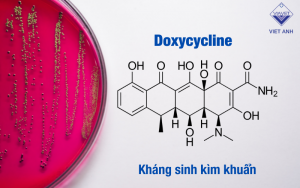
2 10

Doxycycline được biến đến là một kháng sinh rất phổ biến trong ngành thú y. Tuy nhiên không phải ai cũng hiểu và biết cách sử dụng kháng sinh sao cho đúng cách. Bài viết dưới đây Việt Anh Viavet sẽ cung cấp tới bạn đọc những thông tin hữu ích nhất liên quan đến kháng sinh doxycycline, đặc biệt là ứng dụng và việc sử dụng trong ngành thú y.
Mục lục
* Tổng quan về kháng sinh Doxycycline
* Ứng dụng của kháng sinh Doxycycline trong ngành thú y
* Hướng dẫn sử dụng doxycycline đúng cách

* Tổng quan về kháng sinh Doxycycline
– Phân nhóm kháng sinh
- Doxycycline là kháng sinh điển hình thuốc phân nhóm Tetracycline, đây là nhóm kháng sinh có tác dụng kìm khuẩn và có phổ tác dụng rộng nhất trong nhóm các kháng sinh hiện có. Các kháng sinh thuộc nhóm tetracycline bao gồm doxycycline đều là các kháng sinh có 4 vòng 6 cạnh và được lấy từ Streptomyces aureofaciens hoặc được bán tổng hợp thành.
– Cơ chế tác dụng và phổ tác dụng
- Nhóm tetracyclin được biết đến là nhóm kháng sinh có tác dụng kìm khuẩn, có phổ kháng khuẩn rộng nhất trong các kháng sinh hiện có. Các kháng sinh thuộc nhóm tetracyclin bao gồm doxycycline đều có phổ tương tự, trừ minocyclin: hiện nay đã có một số chủng vi khuẩn đã xuất hiện tình trạng kháng với tetracyclin khác có thể vẫn còn nhạy cảm với minocyclin.
Tác dụng kìm khuẩn của nhóm tetracycline được xác định là do ức chế sự tổng hợp protein của vi khuẩn. Các kháng sinh nhóm tetracyclin có tác dụng trên:
- Nhóm cầu khuẩn gram (+) và gram (-)
- Nhóm trực khuẩn gram (+) yếm khí và ái khí
- Nhóm trực khuẩn gram (-).
– Dược động học
- Dù thuộc nhóm tetracyclin, tuy nhiên Doxycycline có một điểm khác biệt so với các hoạt chất khác cùng nhóm đó là tính chất tan tốt trong lipid, do đó doxycycline được hấp thụ tốt hơn qua đường tiêu hóa và có khả năng đi xuyên qua màng tế bào vi khuẩn nhanh nhất và dễ dàng nhất trong nhóm kháng sinh tetracycline.
- Doxycycline được cơ thể hấp thụ theo cơ chế theo máu về gan do đó hoạt chất được phân hủy tại gan, theo mật xuống ruột và đào thải qua phân ở dạng không còn hoạt tính. Do đó doxycycline không diệt hệ vi khuẩn đường ruột.
* Ứng dụng của kháng sinh Doxycycline trong ngành thú y
- Được biết đến là kháng sinh có phổ tác dụng khá rộng trên cả người và thú y. Doxycycline trong ngành thú y được chỉ định sử dụng trong 1 số trường hợp sau:
- Các bệnh lý có nguyên nhân phát sinh do nhiễm khuẩn các chủng vi khuẩn như Sraphylococcus spp, Streptococus spp, E.coli,…
- Điều trị các triệu chứng da nhiễm mủ, viêm mủ, viêm phế quản, viêm phổi, nhiễm khuẩn dạ dày, ruột,…

- Trong ngành chăn nuôi thủy hải sản, doxycycline thường được sử dụng để điều trị các bệnh lý do các vi khuẩn như Pseudomonas, Edwardsiella, Vibrio, Aeromaonas, Streptococcus gây ra với các triệu chứng bệnh lý như lở loét, gan thận có mủ, đốm đỏ, đốm trắng, xuất huyết toàn thân hoặc xuất hiện tình trạng đỏ vòm miệng. Đặc biệt doxycycline rất hiệu quả trong điều trị trường hợp gan thận mủ, xuất huyết.
- Bên cạnh đó, doxycycline còn có tác dụng dự phòng các bệnh do vi khuẩn nhạy cảm với doxycycline gây ra như: Hoại tử gan tụy gây hiện tượng tôm chết sớm, bệnh phân trắng, rụng râu, gãy càng do nhiễm vi khuẩn Vibrio spp., điều trị sưng, chướng bụng, gan thận mủ, xuất huyết trên thân, xuất huyết vây, nổ tròng mắt trên cá.
* Hướng dẫn sử dụng doxycycline đúng cách
- Hiện nay trên thị trường doxycycline được bào chế sản xuất dưới 1 số dạng bào chế như thuốc tiêm, dạng bột pha trộn với thức ăn,nước uống,… với các hàm lượng khác nhau phục vụ cho mục đích dự phòng, điều trị cho các loài động vật khác nhau trong các bệnh lý khác nhau.
- Để việc sử dụng Doxycycline hiệu quả, người tiêu dùng cần chọn được chế phẩm với liều lượng cách dùng phù hợp với vật nuôi và bệnh lý cần điều trị. Trong quá trình sử dụng cần tuân thủ các hướng dẫn của nhà sản xuất được quy định trên bao bì đóng gói về liều lượng và cách dùng đúng trên mỗi vật nuôi và tình trạng bệnh. Sau khi sử dụng cần theo dõi các vấn đề tác dụng phụ liên quan trên vật nuôi được khuyến cáo để có thể xử lý kịp thời các tình huống bất ngờ phát sinh.
Vì tình trạng kháng kháng sinh và tồn dư kháng sinh ngày càng trở nên vật nuôi ngày càng trở nên phổ biến vì vậy cần thận trọng và tham khảo thêm ý kiến từ các chuyên gia y tế trong ngành về việc sử dụng thuốc kháng sinh (nếu vật nuôi của bạn thường xuyên cần sử dụng và phải sử dụng trên quy mô lớn)
Hy vọng các thông tin về Doxycycline được cung cấp từ các chuyên gia y tế của Việt Anh Viavet đã giúp bạn đọc có thêm nhiều góc nhìn hơn về dòng kháng sinh phổ biến này.
Mời đón đọc thêm các bài biết chuyên khoa từ Việt Anh Viavet và tìm hiểu thêm về các sản phẩm chất lượng của công ty.
















